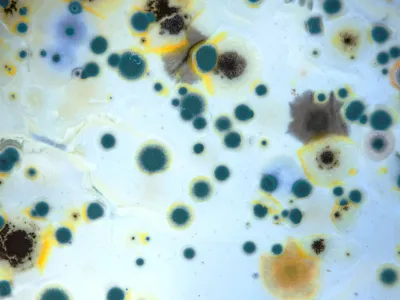
Plíseň na zdi, jak se ji zbavit?

Vyberte si z naší nabídky
Produkty v akci
Vybráno pro vás
Doprava od 3 tis. zdarma
Naše kvalitní interní doprava se přizpůsobí Vašim individuálním požadavkům.
Slevy pro firmy a školy
Pro firmy a školy máme připravené výhodnější ceny a extra služby.
Náhradní plnění
Firmám a školám poskytujeme náhradní plnění. Podpořte naše znevýhodněné zaměstnance.
Poradí Vám odborníci
Poradíme Vám, jak ušetřit na profesionálním úklidu a zachovat vysokou kvalitu.